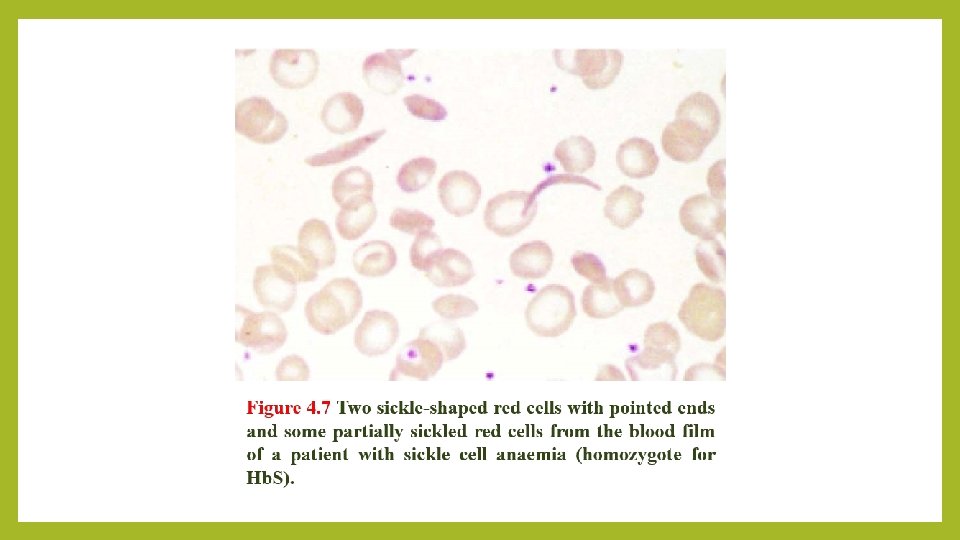
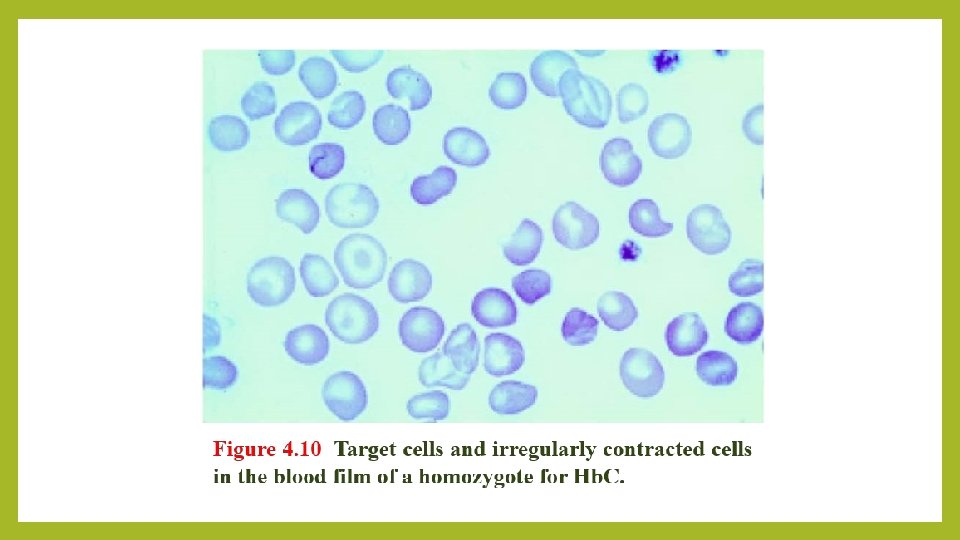

DISORDERS OF GLOBIN SYNTHESIS BY DR FATMA ALQAHTANI

DISORDERS OF GLOBIN SYNTHESIS BY: DR. FATMA AL-QAHTANI

LEARNING OBJECTIVES § To understand the normal structure and function of hemoglobin and how the globin components of hemoglobin change during development, and postnatally. § To understand the mechanisms by which the thalassaemias arise § To appreciate the clinical presentations and complications of thalassaemia § To appreciate the contribution of haemolysis and ineffective erythropoiesis to the pathophysiology of thalassaemia § To understand the pathophysiology of sickle cell anaemia § To be able to describe the clinical presentation and complications of sickle cell anaemia § To understand the role of haemoglobin electrophoresis and high performance liquid chromatography in the investigation of globin disorders § To appreciate the many other haemoglobin variants associated with disease

Normal Structure and function of Hemoglobin ØHemoglobin is critical to the normal function of the red cell, the fundamental role of which is the transport of oxygen from the lungs to the tissues. ØThe normal tetramer hemoglobin molecule comprises two ‘alphalike’ globin polypeptide chains and two ‘beta-like’ globin chains; each globin molecule is associated with a hem group, which comprises a porphyrin ring with iron in its ferrous form at the center. ØThe α chains are encoded on chromosome 16. ØThe β-like globins are encoded on chromosome 11.


cont’d… ØFetal haemoglobin Hb. F (α 2γ 2) ØThe major adult haemoglobin is Hb. A (α 2β 2) with a much smaller contribution from Hb. A 2 (α 2δ 2 - usually 1. 5 -3. 5% of adult haemoglobins). ØThe fetal haemoglobin Hb. F has a higher oxygen affinity than the adult haemoglobins, facilitating transfer of oxygen from the maternal to the fetal circulation. ØNormally, the synthesis of α-like and β-like chains is balanced. ØAn imbalance between the production of α and β chains is the pathophysiological basis of the thalassemias (a quantitative issue).


Thalassemia • The thalassemias are divided into two main groups, the α-thalassemias and the β-thalassemias, depending on whether the defect lies in the synthesis. • Its pathophysiology includes the chains which are present in excess will precipitate in the precursor red cells, leading to their premature death prior to release from the bone marrow (ineffective erythropoiesis) resulting to an increased erythroid drive and further expansion of the marrow into bones not typically used for hemopoiesis, and into the spleen. • Thus, the long-term consequences of thalassemia therefore include splenomegaly, bony deformities and iron overload due to transfusion and infective erythropoiesis as well as chronic anemia.


α-Thalassemia vα-Thalassemia is seen with the greatest frequency in south-east Asia (Thailand, the Malay Peninsula and Indonesia) and west Africa. v. Each chromosome 16 has an α-globin locus consisting of two α-globin (i. e; 4 genes) genes plus the regulatory sequences essential for their normal expression. v. In most patients with α-thalassemia, there is a deletion of one or more of the α-globin genes; there are occasional cases that are the consequence of non-deletional defects.

cont’d… v. Deletion of one or two genes causes an asymptomatic condition with minor hematological features; deletion of three of the four α-globin genes causes a more severe imbalance of α: β-globin chains and results in hemoglobin H, four beta globins, disease; and loss of all four α-globin genes causes Hb Bart’s, four gamma globins, (hydrops fetalis syndrome). v 0. 4% of deliveries are stillbirths due to Hb Bart’s hydrops fetalis syndrome and Hb. H disease is found in about 1% of the population.

α+-Thalassemia trait (deletion of one α globin gene) • This is seen when an individual inherits the α+-thalassemia allele from one parent and a normal chromosome 16 from the other parent (i. e. heterozygotes for the α+ determinant). • Affected individuals are asymptomatic, although they have minor hematological changes such as slight reductions in mean cell volume (MCV) and mean cell hemoglobin (MCH).

0 α -Thalassaemia trait (deletion of both α-globin genes in same allele on ch 16) The Hb is either normal or slightly reduced and the MCV and MCH are low. However, RBC count is elevated and RDW is not affected (why? ).

Hemoglobin H disease (deletion of three α-globin genes) ØThis chronic hemolytic anemia results from the inheritance of both the α+and α 0 -thalassaemia alleles, leaving one functioning α-globin gene per cell. Ø α-globin chains are produced at very low rates, leaving a considerable excess of β-chains, which combine to form tetramers (β 4). This tetramer is known as Hb. H. ØHb. H is unstable and precipitates as the erythrocytes age, forming rigid membrane-bound inclusions that are removed during the passage of affected red cells through the spleen. ØThe damage to the membrane brought about by this removal results in a shortened red cell lifespan.

cont’d… ØMost patients are moderately affected, with a mild anemia of 7 -11 g/dl and markedly hypochromic, microcytic indices. ØSupravital staining of the blood film demonstrates cells with many Hb. H inclusions, giving a characteristic ‘golf-ball’ appearance. ØMost patients will be transfusion independent. ØSplenomegaly is seen in most patients.



Hb Bart’s hydrops fetalis syndrome (deletion of all four α-globin genes) No α-chains can be formed, and the fetal β-like chain γglobin forms tetramers known as Hb Bart’s. This hemoglobin is not useful for oxygen transport and, despite the persistence of the embryonic hemoglobin Hb Portland (ζ 2γ 2), there is intrauterine or neonatal death due to hydrops.

β-Thalassemia § The World Health Organization estimates that 1. 5% of the world’s population are carriers of β-thalassemia. The prevalence of the βthalassemia trait is particularly high in southern Europe (10 -30%) and south-east Asia (5%), common in Africa, the Middle East, India, Pakistan and southern China. § α-thalassaemia typically arises from gene deletions. § β-thalassaemia usually results from a multiplicity of different single nucleotide substitutions, insertions or small deletions affecting the βgene itself or occasionally in promoting regions.

Heterozygous β-thalassemia (Beta-thalassemia trait) • Most affected subjects with beta thalassemia trait are asymptomatic. • The Hb concentration is either normal or slightly reduced, hypochromic and microcytic red cell indices are seen. • Examination of peripheral blood film may show red cell abnormalities such as target cells and poikilocytes. • β-thalassemia Hb. A 2 levels will be raised above the normal range to 3. 57. 0%. Sometimes, a slightly increased Hb F levels, in the range of 1 -5%.

Homozygous β-Thalassemia • Defects of β-globin on both copies of chromosome 11. • Marked anemia. • Transfusion dependent.

Clinical classification of the thalassemias 1) Thalassemia minima describes the presence of a thalassemia mutation that is without clinical consequences. 2) Thalassemia minor describes patients with microcytosis and hypochromic red cells secondary to thalassemia mutations, but with only mild anemia or a normal hemoglobin. Patients who inherit a single affected allele are usually in this category.

cont’d… 3) Thalassemia intermedia patients will also have a microcytic hypochromic anemia, increased erythroid drive to maintain their hemoglobin, packed bone marrow with a decreased myeloid to erythroid ratio, and extramedullary hematopoiesis, giving splenomegaly. Transfusion may be required to maintain the hemoglobin at times of additional physiological stress. 4) Thalassemia major have severe anemia and are transfusion dependent. Their increased erythroid drive leads to a packed erythroid marrow and splenomegaly, development of bony abnormalities secondary to unchecked marrow expansion. Patients in this category are those with complete loss of β-globin expression from both copies of Ch 11.

The clinical course and complications of thalassemia major Anemia - is the principal feature of thalassemia major, the massive expansion of erythroid activity results in several complications: a) Splenomegaly. b) Bony deformities. c) Growth retardation. d) Iron absorption from the gut is increased. e) Marked iron overload. Iron deposition due to overload occurs in the myocardium, resulting in congestive cardiac failure and potentially fatal arrhythmias; in the liver, leading to cirrhosis; in the pancreas, causing diabetes mellitus; and in other endocrine organs, leading to delayed puberty.

Treatment of β-thalassemia major 1) 2) 3) 4) 5) Transfusion are planned to maintain the pre-transfusion Hb concentration at 9 -10 g/d. L or above. Splenectomy can be performed. Iron chelator, required subcutaneous infusion treatment over several hours on five days of the week. Hematopoietic stem cell transplantation (HSCT) is curative. Gene therapy (see the NEJM quick tack, https: //www. nejm. org/do/10. 1056/NEJMdo 005273/full/).

Genetic counselling and antenatal diagnosis of β-thalassemia major • Antenatal diagnosis can be made early during pregnancy from an analysis of chorionic villous DNA (at 9 -12 weeks) or amniocyte DNA (at 13 -16 weeks), or later using DNA from blood obtained from an 1820 -week-old fetus. • Newer techniques focus on the non-invasive analysis of fetal DNA in the maternal circulation. • A pre-marital screening, national program, is one of the major intervention leading to reduced incidence of beta thal major.


Structural Hemoglobin Variants Over 1000 abnormal hemoglobin variants have been reported. The majority of structural Hb variants are the consequence of a single-point mutation with a single amino acid substitution in the affected globin chain (e. g. Hb. S, Hb. E, Hb. C and Hb. D). • When the amino acid substitution results in an overall change in the charge of the hemoglobin molecule, its migration in a voltage gradient is altered and this can be demonstrated by standard electrophoretic techniques. The speed of migration is characteristic for each abnormal hemoglobin. • Abnormal hemoglobin variants are now usually detected by high-performance liquid chromatography (HPLC). The most common structural Hb variant is hemoglobin S (Hb. S). •


Hemoglobin S §A mutation in the β-globin gene results in the charged glutamic acid residue in position 6 of the normal β-chain being replaced by an uncharged valine molecule. § The interaction of sickle β-globin chains with normal α-globin chains forms Hb. S. § When deoxygenated, Hb. S is much less soluble than deoxygenated Hb. A, and Hb. S molecules polymerize, eventually forming long fibers. These result in the deformation of the cell into the well-recognized sickle shape.

Sickle Cell Trait o. Heterozygotes (one gene for normal β-globin and one for βS) are described as having sickle cell trait. Their red cells contain between 20% and 45% Hb. S, the rest being mainly Hb. A. o. Individuals with sickle cell trait are usually asymptomatic. However, spontaneous hematuria may occur occasionally due to microvascular infarctions in the renal medulla. Renal papillary necrosis may rarely occur. The red cells do not sickle until the O 2 saturation falls below 40%.

Sickle Cell Anemia v. It is a descriptive name when patient have at least a copy of beta globin being S and another beta harbor any mutations (beta that/S, S/D, ect). v. Homozygotes for sickle β-globin are described as having sickle-cell anemia. Their red cells contain almost exclusively Hb. S and NO Hb. A; there is a small but variable percentage of fetal hemoglobin. v. Sickled red cells then occlude the microvasculature, with poor downstream perfusion and oxygenation. They may be lysed directly in the circulation, where the resulting free hemoglobin scavenges nitric oxide. v. Hb. S are less deformable than normal red cells and this results in a chronic, extravascular, hemolytic anaemia. The Hb usually varies between 6 and 9 g/d. L.

Diagnosis ØSickled cells are invariably present on the blood films of patients with Hb. SS is made by finding; Ø(i) a positive result with a screening test for Hb. S (Sickle solubility test); and Ø(ii) a peak at an appropriate position on an HPLC trace, confirmed by isoelectric focusing or hemoglobin electrophoresis. ØIn young children, a classic acute painful presentation is with dactylitis, or the ‘handfoot syndrome’, in which there is occlusion of the nutrient arteries to the metacarpals and metatarsals (Figure 4. 8) and painful swelling of the hands and feet. ØIn the central nervous system, cerebral infarction occurs in approximately 10% of patients under the age of 20, and is a cause of significant morbidity in sickle cell patients. It has been found that children with an increased velocity of blood flow in the major cerebral vessels are at particular risk of stroke.




Treatment The principles of the management of sickle cell anemia include: 1) Management of the increased infection risk by immunization. 2) Administration of folic acid daily to prevent secondary folate deficiency. 3) Avoidance of factors precipitating painful crises such as dehydration, hypoxia, circulatory stasis. 4) Treatment of painful crises with oral or intravenous fluids and analgesics, including opiates when necessary. 5) Early detection of the acute chest syndrome (blood gas measurements and chest X-ray). Exchange transfusions are often needed to lower the patient’s Hb. S levels and limit ongoing sickling. 6) Blood transfusion when necessary.

Hemoglobin E and C Among the commonest are Hb. E and Hb. C, both of which result from single amino acid substitutions in the β-chains. • Hb. E is very common in south-east Asia (being found in about 50% of the population in some parts of Thailand). • Hb. C is the consequence of a glutamine to lysine substitution in the β-globin chain. Hb. C is also seen in homozygosity; here the hemoglobin does not polymerize as with Hb. SS, but can crystallize, with a resulting reduction in the flexibility of the red cell and a reduction in its survival. • Homozygotes have a mild anemia, low MCV, splenomegaly and many target cells in their blood film. Hb. C is found in patients of West African origin. • When one allele being S and other being C or E, it is an example of a sickle cell disease (the most benign form is S/E).

Q 1) Which ONE of the following statements is TRUE about sickle cell anemia? • A) The oxygen dissociation curve is shifted to the left. • B) It may cause ankle ulcers. • C) It is NOT associated with stroke. • D) It is NOT associated with atrophy of the spleen

Q 2) Which ONE of the following statements is TRUE about βthalassemia trait? • A) It is associated with a raised hemoglobin A 2 level with normal CBC indices. • B) It is associated with iron overload. • C) It is associated with a normal reticulocyte index. • D) It is associated with splenomegaly.

Q 3) Which ONE of the following statements is TRUE about beta-thalassemia? • A) It may cause hemoglobin H disease. • B) It causes a microcytic hypochromic blood picture. • C) It is frequently cause a hydrops fetalis. • D) It is very common in the Far East.

Q 4) Which ONE of these statements is TRUE about βthalassemia major? • A) It presents at birth. • B) It is usually caused by deletion of β globin genes. • C) It is associated with an increased risk of bone infarction. • D) It is associated with stunted growth.

Q 5) Which ONE of the following is NOT a feature of thalassemia intermedia? • A) It may be due to homozygous βo thalassemia without coinheritance alpha thalassemia. • B) It may be associated with extramedullary hemopoiesis. • C) It is usually associated with splenomegaly. • D) It may cause iron overload.

Q 6) Which ONE of these statements is TRUE concerning sickle cell trait? A) It is a cause of anemia B) It protects against malaria. C) It is usually associated with splenomegaly. D) It is a cause of frequent sickle cells in the peripheral blood

Thank You!!!
- Slides: 46